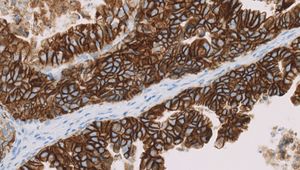

واصمة حيوية
الواصمات الحيوية Biomarker، مصطلح يشير بشكل عام إلى مؤشر قابل للقياس لأحد الحالات أو الظروف الحيوية. أيضا، يستخدم المصطلح أحيانا للإشارة إلى مادة يدل وجودها على وجود كائن حي. علاوة على ذلك، عُرِفت أشكال الحياة بإراقة مواد كيميائية فريدة كالحامض النووي (DNA) في البيئة المحيطة كدليل على وجودها في موقع معين.[1] تقاس الواصمات الحيوية وتُقيّم عادة لفحص العمليات الحيوية الطبيعية، العمليات المُمرِضة، والاستجابة الدوائية لتدخل علاجي. وتستخدم الواصمات الحيوية في عدة حقول علمية أيضا.
تاريخيا
يعود استخدام مصطلح (الواصمات الحيوية) إلى بداية عام 1980[2]. في عام 1988، عرَّفت مجموعة عمل المعاهد الوطنية لتعاريف الواصمات الحيوية الصحية (the National Institutes of Health Biomarkers Definitions) الواصمات الحيوية على أنها "ميزة تقاس وتُقيّم بموضوعية كمؤشرات للعمليات الحيوية الطبيعية، العمليات المُمرِضة، والاستجابة الدوائية لتدخل علاجي." [3][4]
طبيا
في الطب، يمكن أن تكون الواصمات الحيوية مادة يتم إدخالها إلى جسم الكائن الحي بمقدار ضئيل لفحص وظائف الأعضاء أو جوانب صحية أخرى. كمثال، يستخدم كلوريد الروبيديوم كنظير مشع لتقييم التروية الدموية لعضلة القلب. ويمكن أيضا أن تكون مادة يشير وجودها في الجسم لحالة مرضية معينة، كمثال، وجود أجسام مضادة قد يشير إلى وجود عدوى ما. على وجه التحديد، تشير الواصمات الحيوية إلى تغير في تصنيع أو حالة بروتين معين يرتبط بخطر تطور مرض ما، أو مدى حساسية مرض معين لعلاج ما.
تستخدم الواصمات البيوكيميائية عادة في التجارب الدوائية السريرية حيث تؤخذ من سوائل الجسم المتاحة بسهولة لباحثي المراحل المبكرة. وكطريقة مفيدة لمعرفة الأسباب الجينية لمرض معين كمرض انفصام الشخصية فانه يتم استخدام نوع خاص من الواصمات الحيوية يدعى النمط المظهري الباطني.
يمكن أن تعتمد واصمات حيوية أخرى على قياسات النشاط الكهربائي للدماغ (باستخدام تخطيط كهربية الدماغ أو تخطيط مغناطيسية الدماغ) ، أو باستخدام قياسات حجمية لبعض مناطق الدماغ (باستخدام التصوير بالرنين المغناطيسي)، أو بفحص منتجات الأيض في اللعاب مثل نتريت اللعاب كمؤشر بديل لأكسيد النيتريك.
أحد الأمثلة على واصمات حيوية مستخدمة بكثرة في الطب مستضد البروستات المحدد ((PSA. يقاس هذا المؤشر كبديل لحجم البروستات ذي التغيرات السريعة التي يحتمل أن تشير إلى السرطان.
توثيق مصداقية الواصمات الحيوية التنظيمي
إثبات المفهوم استخدم سابقا لتحديد الخصائص الدقيقة للواصمات الحيوية، وهذه الخطوة مهمة لتوثيق مصداقية فوائدها في الموقع الأصلي. يجب اختبار عدد كبير من الواصمات الحيوية المرشحة لاختيار الأكثر مواءمة.[5]
توثيق المصداقية التجريبي تسمح هذه الخطوة بتطوير البروتوكولات الأكثر تبنيا للاستخدام الروتيني للواصمات الحيوية. تزامنا، فإنه من الممكن تأكيد مواءمة البروتوكول بعدة طرق (علم الأنسجة، PCR، ELISA...) وتعريف الطبقات بناء على النتائج.
توثيق المصداقية للأداء التحليلي أحد أهم الخطوات، تخدم في التعرف على الخصائص الدقيقة للواصمات الحيوية المرشحة قبل تطوير الفحص الروتيني لها. تؤخذ عدة متغيرات في عين الاعتبار وتتضمن: - الحساسية - النوعية - المتانة - الصحة -قابلية التكرار[6]
معايرة البروتوكول هذا يحسن البروتوكول الموثق للاستخدام الروتيني متضمنا تحليل النقاط الحرجة من خلال الفحص الدقيق لكل الإجراءات لأجل التعرف على المخاطر المحتملة والحماية منها.
أحياء الخلية
في أحياء الخلية، الواصمات الحيوية هي جزيئات تسمح بكشف وعزل نوع معين من الخلايا (كمثال، البروتين Oct-4 يستخدم كواصمة حيوية للتعرف على الخلايا الجذعية الجنينية).[7] في علم الوراثة، الواصمات الحيوية (وتعرف بالواصمات الجينية) هي سلسلة DNA تسبب مرض أو مرتبطة بالقابلية لمرض معين. وقد اعتادوا على إعداد خرائط جينية لأي كائن تتم دراسته.
علوم الأرض وعلم الأحياء الفلكية
الواصمات الحيوية يمكن أن تكون أي جزيء يشير الى وجود أي كائن حي في الماضي أو الحاضر. في حقول علوم الأرض وعلم الأحياء الفلكية، تعرف الواصمات الحيوية بالتواقيع الحيوية أيضا. يستخدم مصطلح الواصمة الحيوية أيضا لوصف التدخل الحيوي في توليد البترول.
علم السموم البيئية
تستخدم الواصمات الحيوية لتشير للتعرض لتأثير أجنبي بيولوجيا يتواجد في البيئة وفي الكائنات الحية. الواصمة الحيوية قد تكون مادة خارجية بذاتها (مثل: الحرير الصخري ، وNNK من التبغ)، أو متغير معالج من المادة الخارجية من قبل الجسم (ناتج أيض) يمكن تحديد كميته.
انظر أيضاً
المراجع
- ^ Zimmer, Carl (January 22, 2015). "Even Elusive Animals Leave DNA, and Clues, Behind". نيويورك تايمز. Retrieved January 23, 2015.
- ^ Aronson, Jeffrey (2005). "Biomarkers and surrogate endpoints". British Journal of Clinical Pharmacology. 59 (5): 491–494. doi:10.1111/j.1365-2125.2005.02435.x. PMC 1884846. PMID 15842546. Retrieved 17 July 2013.
- ^ Strimbu, Kyle; Jorge, Tavel (2010). "What are Biomarkers?". Current Opinion in HIV and AIDS. 5 (6): 463–466. doi:10.1097/COH.0b013e32833ed177. PMC 3078627. PMID 20978388.
{{cite journal}}
:|access-date=
requires|url=
(help) - ^ "Biomarkers and surrogate endpoints: preferred definitions and conceptual framework". Clinical Pharmacology & Therapeutics. 69 (3): 89–95. 2001. doi:10.1067/mcp.2001.113989. PMID 11240971. Retrieved 17 July 2013.
- ^ "Proof-of-concept study of biomarker development in mice provides a roadmap for a similar approach in humans". www.fredhutch.org. Retrieved 2015-05-13.
- ^ "http://www.fda.gov/downloads/Drugs/NewsEvents/UCM300731.pdf" (PDF). www.fda.gov. Retrieved 2015-05-13.
{{cite web}}
: External link in
(help)|title=
- ^ Biomarkers for Psychiatric Disorders. Publisher: Springer U.S. DOI:10.1007/978-0-387-79251-4 Copyright: 2009 ISBN 978-0-387-79250-7 (Print) 978-0-387-79251-4 (Online)